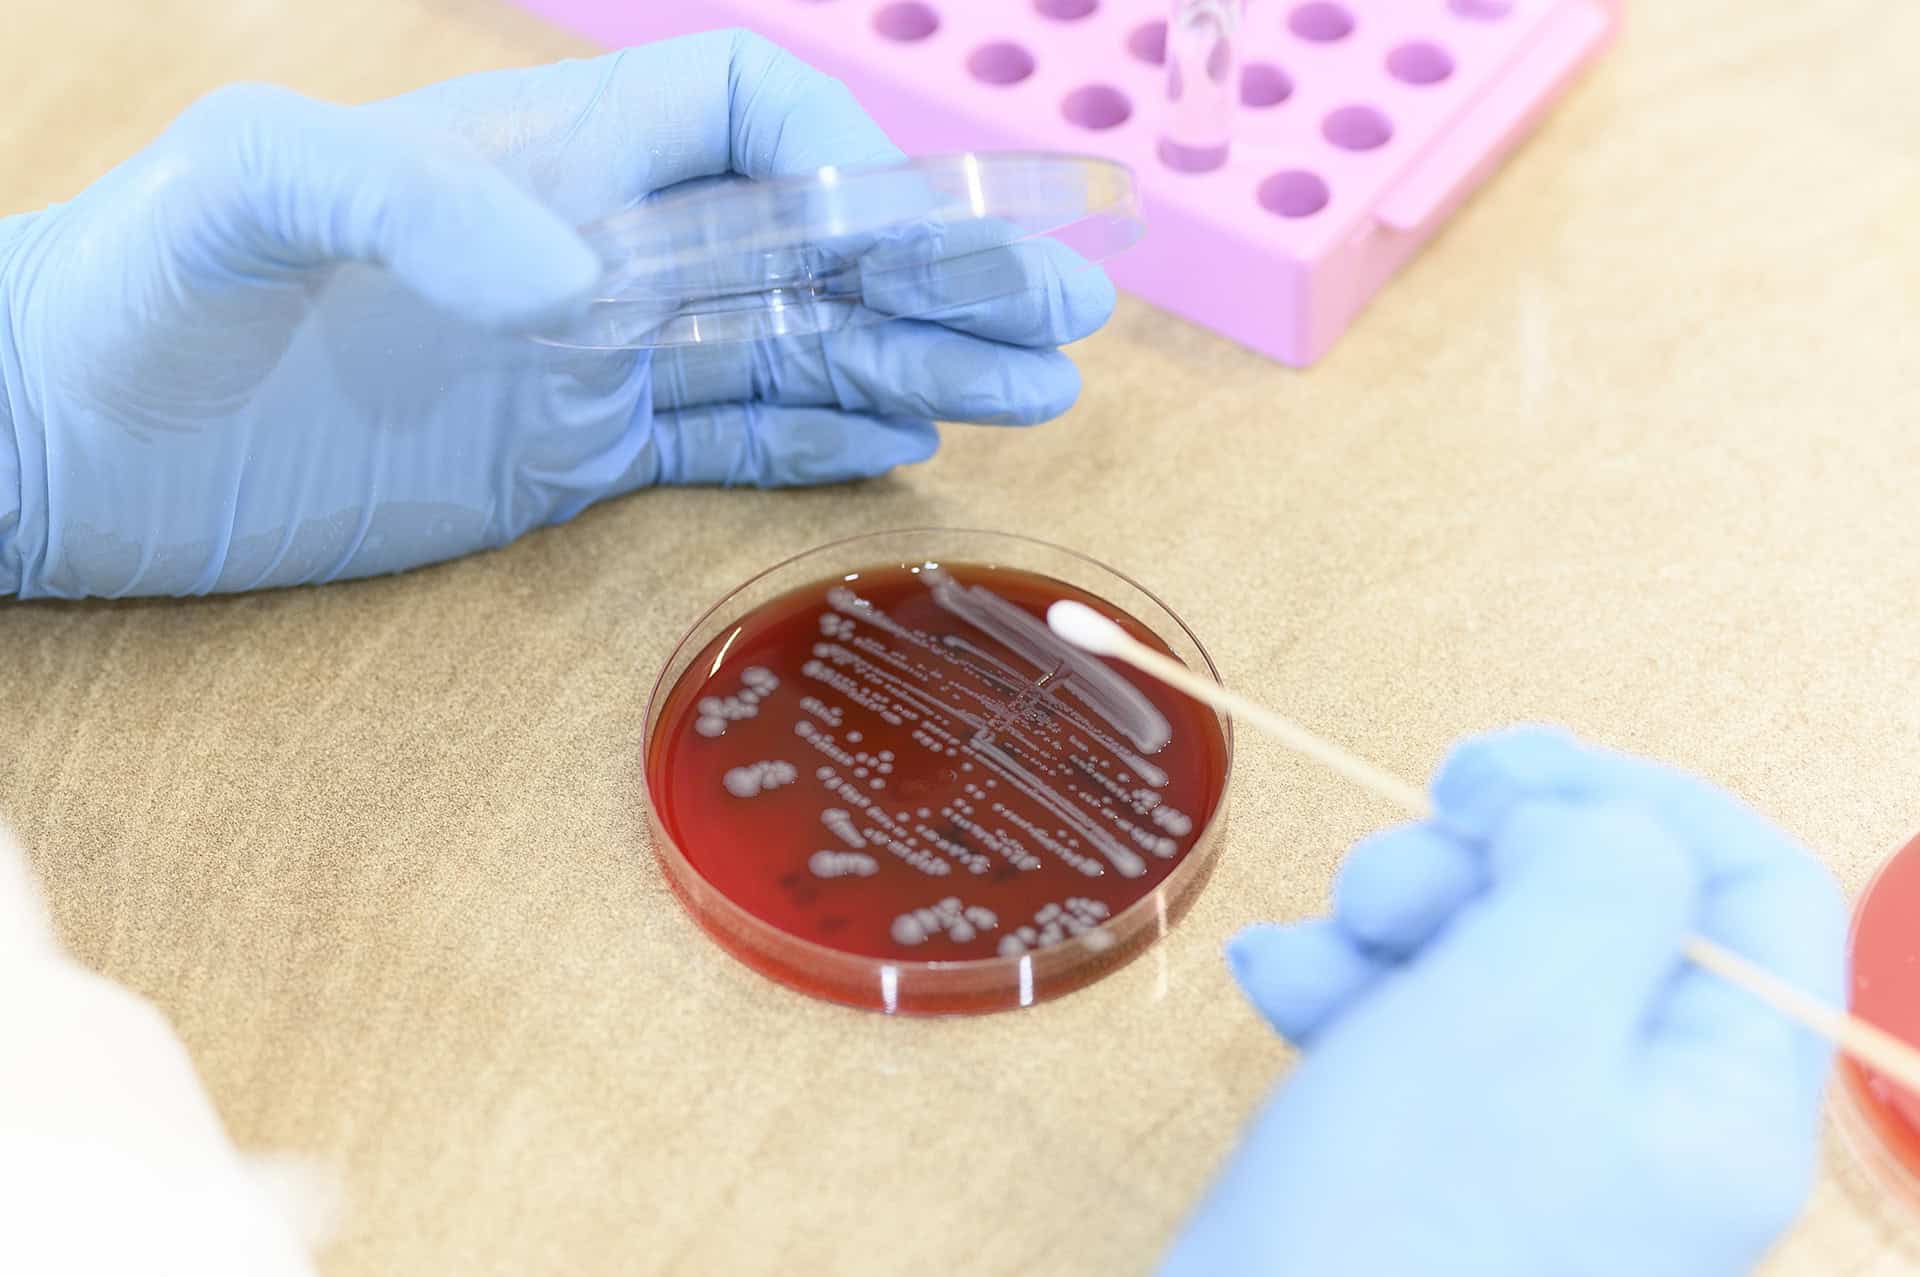
Eliava Foundation

The Eliava Institute was founded in 1923 by distinguished Georgian physician, bacteriologist and phage researcher Prof. Giorgi Eliava. An extraordinary role in the institute’s development was played by famous French-Canadian scientist Felix d’Herelle, who co-discovered bacteriophages. These scientists were united around the idea of creating a world centre of phage research and phage therapy in Tbilisi, Georgia.

Eliava BioPreparations LTD is a pharmaceutical company manufacturing bacteriophage preparations for combating the spread of bacterial infections. EBP was founded in 2008 by Eliava Foundation. The company became a proud member of the Eliava Consortium and started working on production, modernization, and development of phage preparations.

Eliava Phage therapy Center (EPTC) is one of the few centres in the world dedicated to phage therapy. It is one of the members of Eliava Consortium. Eliava Phage Therapy Center has specialists in the fields of pediatrics, internal medicine, urology, gynecology. EPTC offers outpatient surgical consultations for those patients, whose treatment strategies include the use of bacteriophage as the cornerstone of complex medical service.

The company was established in 1990 by the leading scientists of "The Eliava Institute of Bacteriophage, Microbiology, and Virology" - in order to develop new services on the market in connection to phage therapy. The Center is focused on medical diagnostic services.

Eliava Authorized Pharmacy is an experienced pharmaceutical company that offers a big variety of medications and phage products not just for the treatment of infectious diseases, but also for prophylactic purposes. The pharmacy has a special license from the Ministry of Labor, Health, and Social Affairs of Georgia for the development and production of personalized phage preparations - autophages. Autophages are tailored for each patient’s very specific needs.ი სერვისია.

Eliava Phage Service (EPS) is a company focused on application of phage-based products for environmental protection, sanitation and decontamination of different environments contaminated with bacterial pathogens. EPS provides services of evaluation of the level of bacterial contamination in medical settings, identification of causes of hospital (nosocomial) infections, selection of appropriate specific bacteriophages against contaminating bacterial agents and application of phages with help of a specific device – fogger.

Bacteriophages
What is a Phage?
Bacteriophages are “good” viruses that destroy only “bad” bacteria that cause infectious disease; it doesn’t affect normal microflora. Phage recognizes so called host bacteria, attaches to it and injects its genetic material into the cell. It actively multiplies inside the cell and lysis it. Like other viruses, bacteriophages vary a lot in their shape and genetic material. Bacteriophages are widespread in the environment and are actively involved in various important ecological processes.